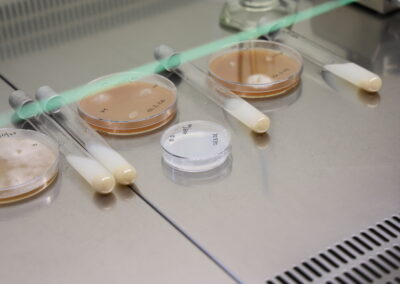

MY JSME VÚK! Rozhovor s Karlem Černým
PDF FORMÁT S OPTIMALIZOVANÝM PÍSMEM JE VÁM K DISPOZICI ZDE
Karel vede na VÚKu odbor biologických rizik a dnes se podíváme na práci, kterou se s jeho týmem zabývají. Kromě fytopatologie se věnují invazním druhům a šlechtění klíčových genotypů na odolnost. Jejich cílem není jen udělat celkový přehled, ale také nabídnout řešení díky výběru klíčových patogenů a klíčových genotypů, zabývají se metodami péče a managementu.
Co Vás přivedlo k tématu biologických rizik?
Je to téma, po kterém je poptávka a vždycky byla. To se týká širšího tématu zdravotního stavu dřevin, který ve VÚKu měl být řešen už kdysi v 70. letech, kdy se o tom začalo uvažovat s epidemií grafiózy. Tehdejší VÚK se tomu chtěl nějakým způsobem věnovat, ale nakonec
z toho bohužel sešlo a převážily fytopatologické aspekty okrasného zahradnictví, hlavně dendrologie. To bylo opravdu na výši; navíc fytopatologie se tady dělala dlouho, posledních zhruba 50 let. Byla to taková užitná fytopatologie, vázaná čistě na okrasný materiál, fungovala jako jakýsi servis pro produkci ústavu.
Říkal jste, že to byla 70. léta?
Ano, ústav má 100 let a prakticky celou dobu ho nějakým způsobem fytopatologie do menší
či větší míry provázela. Ústav přešel v roce 1991 pod MŽP. Ministerstvo si s ústavem moc nevědělo rady a fytopatologie tohoto ražení pro něj nebyla podstatná. To, že fytopatologie tady nějakým způsobem na výborné úrovni přežívala, je věc druhá, ale poptávka po ní ze strany zřizovatele nebyla. Lesnická fytopatologie se dělala vždy v Brně, v Praze a ve Strnadech. Úroveň byla proměnlivá, někdy lepší, někdy horší. Pak se tématu začala věnovat ještě AOPK začátkem 90. let na odboru dendrologie. Tam se zabývali zdravotním stavem dřevin urbánní vegetace, která spadala pod AOPK. Ta organizace je obtížná, správa je různá, ale agentura měla know-how a sloužila i jako zázemí pro samosprávy, které se potřebovaly někdy informovat, co
s vegetací při příčném poškození atd.
Proč jste se rozhodl pro tento obor?
Jsem mykolog z Karlovy univerzity a hledal jsem práci. Nejprve jsem na agentuře pracoval jako fytopatolog. To pracoviště se později přejmenovalo na oddělení biologických rizik a přebíralo už tehdy invazní agendu, řešili jsme invazní dřeviny. Při transformaci VÚKu někdy kolem roku 2011/2012 vznikl odbor zde. A tam bylo cílem už aktivně reagovat na poptávku, navázat činnost na potenciální poptávku ministerstva nebo ji vytvářet, protože přístup ochrany přírody tenkrát byl takový, že příroda si s tím poradí sama.
Cílem práce našeho týmu bylo dát dohromady specializace, které by pokryly klíčové aspekty budoucí práce a poukázat na patogeny, které jsou podstatné. To jsou v podstatě ty nepůvodní, invazní; ty jsme pak směrem do obecnějšího povědomí lidí kolem životního prostředí prezentovali s informací: toto jsou invazní organismy a musí se s nimi zacházet jinak než s normálními patogeny a jsou podstatnou částí neobioty, rovnocennou, což je naše téma doteď.
Patří sem rozhodně vytrvalá práce lidí, kteří za tím stojí, protože díky nim se vše podařilo postupně prosadit a nebylo to vůbec lehké; nebýt osvícených lidí na ministerstvu jako je třeba pan Šíma a další, tak by potřebné změny nenastaly dosud. Desetiletí jsme se setkávali s totálním odmítáním. A jen sledovali, jak se náskok, který máme, pomalu tenčí. Ale nemůžu si stěžovat, protože se nám toho hodně podařilo. Po dvaceti letech máme konečně důkladný checklist invazních druhů, z kterého se dá vycházet, a to včetně důležitých témat, která jsou na to navázaná…
Co Vás na přírodě v souvislosti s Vaší profesí nejvíce fascinuje?
(smích) Mě práce deformuje, jako každého, to je normální. Jdu do lesa a místo toho, abych si užíval, že stromy jsou zelené, vidím, že tento má tuto chorobu, tento má tohle a tak podobně.
Naším tématem je neobiota, fytopatogenní mikroorganismy, houby. A cílem není jen udělat celkový přehled, ale také nabídnout řešení, vybrat klíčové patogeny, klíčové druhy – key stone species – a hledat metody péče nebo managementu. Těch metod je celá řada, od možností vymýcení (eradikace) nebo zmírňování negativních dopadů (mitigace) ve školkách až po omezování v terénu: u některých druhů, které se v terénu šíří pomalu, to funguje. Některé lesníky téma zajímá a snaží se s tím něco dělat a pomáhají tak omezovat šíření. Jenomže většina z těchto druhů se šíří nenápadně, plošně, rychle, to nám zbývají jen adaptace. Tam je pak potřeba upravovat hospodářská opatření v lesích a dělat predikce, abychom věděli, kde má cenu se na to soustředit…
Jak může odbor biologických rizik pomoci české krajině?
Těch možností je celá řada. To, co dělá třeba Petra Štochlová od nás z týmu a lidi kolem ní, je další klíčová věc. Zkoumají topol černý, i když toho žádný patogen nevytloukl, toho vytlouklo stupidní chování lidí, vlastně nezáměrné. Tím, jak přetváříme krajinu, tak některé organismy na to doplácí – a topol černý je jedním z nich. Jeho populace je redukovaná ne proto, že má nějaký patogen, ale proto, že se neobnovuje a mizí úplně stejně jako ostatní klíčové taxony.
My neděláme nějaké vzácné dřeviny, to není naše poslání. My se zabýváme klíčovými druhy, na kterých stojí systémy. A kolegové se pak věnují šlechtění na odolnost, což je klíčová věc. Je to záležitost dlouhodobá, protože naším cílem je získat genotypy a genofond odolných genotypů, které můžeme dosazovat zpátky do přírody a používat je aspoň lokálně tak, abychom udrželi důležitého hostitele v systému.
Typicky je to třeba olše lepkavá, kde program je nejdál, pracuje se na něm asi 15 let, takže výsledky už tam jsou. Zájem o produkty je například ze strany Povodí, protože olše je jedním z taxonů, které jsou klíčové v břehových porostech. Ty byly vždycky v krajině opomíjené, ale je to unikátní systém z řady důvodů: má obrovský krajinotvorný dopad a důležité technické funkce (nahrazuje technické opevnění, které sice v krajině nechceme, ale vodní tok musí držet v korytě nebo v linii). Musí být technicky funkční a stabilizovat břehy, to znamená, že musí vyhovovat po environmentální stránce. Tzn. potřebujeme taxony, které tam patří a které fungují, nelze tam mít břízy a osiky, protože to nebude držet; je potřeba mít tam taxony jako jsou olše, jasany, duby. To znamená stromy, které břehy stabilizují. A pokud tyto taxony odchází, tak je břehový porost nestabilní a riziko jeho rozpadu je mnohem větší s tím, že potom se začne hýbat koryto, což je zase problém v majetkoprávních vztazích.
Je to dáno i tím, že se ztrácí přirozená znalost krajiny a rostlin, které mají specifické funkce? Může být jedním z důvodů ztráta přirozené znalosti
a vnímavosti k našemu prostředí?
To je otázka těžká a dobrá. My v krajině pořád žijeme, jen se asi musíme dobře dívat, jak co funguje. A když to vezmeme k břehovým porostům, tak každé povodí má velký počet techniků, kteří tam fungují a měli by mít patřičné znalosti. Protože to není o nějakém velkém vzdělání, nějaké mít je samozřejmě nutné, ale je to spíše otázka na podniky a firmy, aby nabírali zodpovědné a schopné lidi.
Když se každopádně podíváme na staré fotky, břehové porosty v krajině moc nejsou. Krajina je holá a byl na ni také velký tlak, takže jsou tam pak mladé porosty. Nicméně lidé dříve hodně zpevňovali toky, když jim lítaly, protože břehy nebyly zpevněné. Ale tam, kde porosty byly uměle zakládané, se často používaly dřeviny, které tam opravdu patřily a fungovaly. Takže i dnes najdeš pozůstatky porostů zakládaných někdy v 50./60. letech, možná dřív, což znamená, že nejsou až tak staré.
Tam lze vidět, že porosty byly zakládány s rozmyslem, jejich struktura byla jasně daná. Dodnes to lze vidět na některých tocích na Plzeňsku, kdy linie vodního toku přesně v břehu byla poskládaná z olší a vrb. Olše výborně drží břehy, ale mají omezený kořenový systém jen na 6-8 metrů a jejich kořenové systémy se nepropojují, takže tvoří taková oka. Tedy drží dobře břeh, ale vyvrací se. A oni to dosazovali vrbami, které to prorostly a zpevnily a do druhé linie dávali jasany a duby, které mají rozsáhlý kořenový systém (zejména pak jasany, které to celé provázaly, takže celý břeh drží a tvoří jakýsi monolit). Takže i jednotlivé olše, které v tom byly, nevypadly. A toto plánoval a dělal někdo, kdo tomu hodně dobře rozuměl.
Dnes to lidi tolik neumí, i když se to zlepšuje. Problém je v tom, že kolikrát není co do břehového porostu dosazovat, protože klíčové taxony tam nefungují kvůli fytopatogenům. Jasany z krajiny mizí plošně, sice zmlazují, některé z nich přežívat budou, ale nebude to klíčová dřevina. U olší to běží trochu jinak, ale princip je podobný s tím rozdílem, že plíseň olšová se šíří pomalu a lokálně, takže někde ty porosty fungují a někde už nejsou a fungovat nebudou. Po povodních v roce 2002 plošně odumíraly právě olše na tocích řek a předpoklad byl, že je to v důsledku zaplavení. Jenže v té době se šířila plíseň olšová a povodně ji roztáhly po celé krajině – kvůli tomu porosty olší odešly. Nahradily je jasany a zejména vrby.
Jsou změny dány zejména klimatickou změnou?
Konkrétně v tomto případě jde o velký tlak na porosty a zájmy ochrany přírody. Například bobr. Což je úžasný živočich, který leckde funguje dobře, ale dostává se do krajiny, která na něj není přizpůsobená. Takže argument o tom, že bobr v přírodě nevadí a funguje dobře: ano, ale záleží vždy na konkrétní lokalitě. Někde to funguje (např. u Labe u Magdeburgu), někde ne (zničený břehový porost u rybníka, který pak vodní tok nedrží).
Dnes se vše hodně mění a jediné, co pomáhá, je výrazně zvednout biodiverzitu a přemýšlet nad konkrétní mikrolokalitou, přímo nad konkrétními metry břehu a nad tím, co tam vysadit, aby to fungovalo. Porosty dnes nemohou být jedno nebo dvouřadé, ale musí být podstatně širší, což zase klade nároky na majetkoprávní otázky.
Jakým způsobem se vaše know-how předává potom dále do samospráv nebo firem?
My děláme primárně aplikované výstupy, hlavním výstupem je pak metodika a mapa. To znamená, že děláme metodické postupy, jak v konkrétních případech pracovat. Máme metodiky obecné, řešící celkový problém a pak speciální, které se zaměřují na jednotlivé problémy a taxony. Souvisí to samozřejmě s důkladnými predikcemi navázanými na dané lokality.
Které konkrétní subjekty vaše výstupy využívají v praxi?
Je tady řada firem, např. SZKT (Společnost pro zahradní a krajinnou tvorbu), subjektů je dnes oproti minulosti mnoho, což dříve nebylo. I AOPK zjistila, že potřebuje specialisty, nicméně služby aktuálně outsourcuje, což je levnější a chytřejší. Jedná se o dílčí problémy, které si řeší buď samosprávy samy nebo si sjednají soutěž, když je to větší záležitost. Někdo oslovuje nás, ale pro nás to není klíčové téma. Uživateli našich výsledků jsou pak právě např. firmy, které se péčí zabývají.
Jsou tam samozřejmě výzvy, protože pokud někdo ošetřuje strom, který má nějakou chorobu, je potřeba vědět, jaká choroba to je a jak se chová. Např. když v Praze prořezávají javory kleny, které mají cryptostromu corticale (houba), ta funguje jako endofyt (organismus, který žije uvnitř rostlinného pletiva). Ve stromě žije desetiletí a nikdo o ní neví. Pak stačí, aby přišla sušší perioda, stromy mají přísušky, jdou do stresu, v létě je teplo; a houba přejde z endofytického mechanismu k parazitismu. Proroste k povrchu stromu nebo kmene a strom zabije během roku až dvou let. Tady v Praze tu chorobu má zhruba 50 % klenu, což je časovaná bomba. V blbých letech na stresovaných místech, kde přísušky jsou větší, kleny v důsledku této choroby odumírají. Choroba se nachází ve kmenech a větvích, v dřevní části, takže klasické ošetřování dřevin řezem patogen přenáší – skrze nevydezinfikované nářadí. A protože se stromům dost často zkracují kosterní nebo koncové větve (řežou se běžně větve o průměru 10 cm), tak právě tím řezem se houba přenáší po celém stromě a dál po celé výsadbě.
Vůbec jsem netušila, že by se měly dezinfikovat nástroje, kterými se řeže strom!
No, nedělá se to. Ví se, že by se to mělo dělat, ale není to úplně praktické, když člověk visí někde v koruně. Ale když už se přechází mezi stromy, tak by se to dělat mělo nebo je dobré zjistit, v jakém stavu strom je. Typicky v terénu při těžbě v olšinách nebo břehových porostech by se nejdříve mělo pracovat v porostech, které jsou zdravé a nejsou predisponované k rozvoji choroby; a teprve potom pracovat v porostech, které jsou napadené. Některé firmy to tak dělají, dokonce je to někdy specifikované v některých výběrových řízeních.
Jak vypadá den na odboru biologických rizik?
Je to různé. Jsme hodně pestrý tým, a to bychom ještě měli portfolio rozšiřovat. Někteří kolegové jsou vyloženě laboratorní krysy, z laboratoře nevylezou, maximálně, když si jdou pro nějaký vzorek. Máme pěkné sbírky patogenů, které nám slouží jako studijní materiál. Využijeme je i zpětně.
Štěpán teď publikoval článek o plísni olšové, kde srovnává stav před 15 lety se současným stavem: výsledkem je, že se struktura patogenu dramaticky změnila.
Je to molekulárně ekologická studie, obrovsky zajímavá a teď díky ní konečně víme, jak tento druh v přírodě funguje. Zpravidla by to mělo být podobně jako u Covidu – patogen tam vlítne, je virulentní, děsně nebezpečný, probere trochu populaci a aby přežil, postupně mutuje a jeho virulence se postupně snižuje a zároveň se zvyšuje odolnost původně naivní populace. Takto to nějak bývá, ne vždy, ale je předpoklad, že u olše by to zrovna takto mohlo být.
Jaká je největší výzva pro českou krajinu s výhledem na příštích 20 let?
My! Toto jsme si způsobili sami. Ta houba samozřejmě taky, ale ona dělá, co dělat má, chová se přirozeně. To my se chováme… Taky přirozeně – jako houba!
Nepůvodních druhů u nás je aktuálně asi 350. Z toho invazních je 1/10 a 10 druhů z toho může způsobit výraznější změny v prostředí. Problém je v tom, že tady máme jenom 5 nebo 6 taxonů, u kterých už víme, že jsou nebezpečné a všechny už v krajině dokázaly udělat pěknou neplechu. A to, co se šíří dál, je většinou v kulturním prostředí a my přesně nevíme, co to udělá. Proto je dobré modelování, díky tomu predikujeme, že např. klečové porosty na horní hranici lesa mohou začít padat vzhledem k chorobě, kterou jsou napadeny. V Jeseníkách, kde klečové porosty nejsou žádoucí, to vadit nebude, ale může to být problém v Krkonoších. Změny můžeme čekat, otázka je, jak nakonec budou vypadat.
Pak např. u borovice lesní je spouštěčem klimatická změna. Borovice lesní je sice tolerantní ke kolísání spodní hladiny podzemní vody, ale když během suchých let voda klesá podstatně níž než dřív, tak si ty stromy pro ni prostě několik měsíců nesáhnou. Borovice to špatně snáší a objevují se tam potom hodně kůrovci, některé houby se více manifestují a potom porosty borovic rychle odumírají. Je to problém například ve Středních Čechách. Pak je potřeba spoléhat se více na duby, které jsou odolnější a také habr, který lesníci dříve nesnášeli, nebo javory, které to budou schopny tolerovat nějakou dobu. Otázka je, co s tím udělají patogeny.
Třeba u voskovičky jasanové v různých luzích se toho moc udělat nedá, protože prostředí favorizuje patogen, a tím pádem tam jasany prostě nebudou, maximálně jako vtroušená dřevina na extrémních stanovištích na nějakých sušších kopcích. Jasan má nějakou plasticitu, takže tam ta opatření mohou pomoci a on může přežívat a fungovat dobře. Blbé je, že je na něj navázaná poměrně zajímavá složka další bioty. Například smrže a kačenky jsou navázané na jasan jako na dřevinnou složku, jsou to mykorézní houby; a kvůli tomu, že jasany mizí, se mohou omezovat i areály růstu těchto hub. To je jen taková výseč různých aspektů.
Každý strom má své patogeny a škůdce, každý jich má několik desítek, každý je nemocný, je to stejné jako s lidmi. Jde jen o souhru okolností a nějakou citlivost.
Poučenější lidé možná vnímají riziko, rostlinolékaři taky, jenže tlak obchodní sféry je tak silný, že se tomu dá těžko bránit. Můžeme to zpomalovat, šíření a impakt, ale moc se s tím výhledově dělat nedá, budeme na to jen reagovat. Až se problém objeví, tak ho budeme řešit, ale nedaří se nám mu předcházet.
Co byste rád řekl závěrem?
Měli bychom jako lidé být rozumní, když už jsme se tak pojmenovali, ale nevím, no… Jestli bychom se neměli spíš přejmenovat! Změna paradigmatu asi přijde relativně brzy a bude zásadní, jen jde o to, jestli společnost bude dostatečně na výši na to ji přijmout.
Každopádně klima se mění a taxony s ním a nemusí to nutně znamenat nic fatálního…